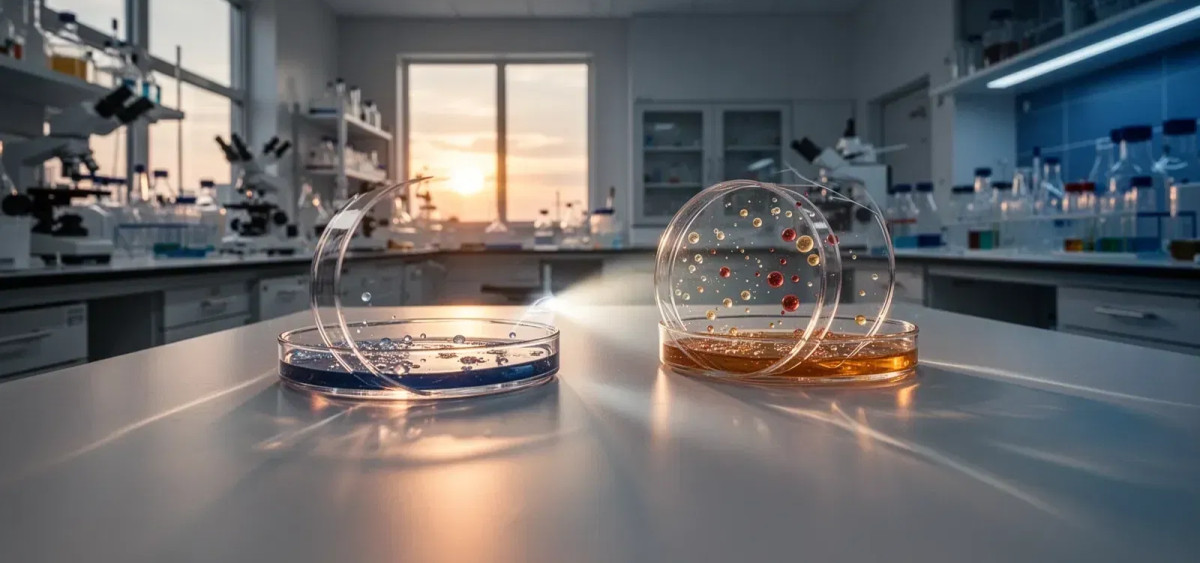
Beitragsbild zu BioNTech Aktie: Positive Dynamik!

BioNTech Aktie: Positive Dynamik!
BioNTech eröffnet kurz vor der Bekanntgabe der Jahreszahlen eine neue juristische Front. Das Mainzer Unternehmen hat Klage gegen den US-Konkurrenten Moderna eingereicht und wirft diesem Patentverletzungen bei dessen neuem Covid-Impfstoff vor. Während die Kassen mit über 17 Milliarden Euro gefüllt sind, rückt damit der Schutz des geistigen Eigentums und die Verteidigung künftiger Marktanteile in den Mittelpunkt.
Juristischer Gegenschlag
Im Kern der Auseinandersetzung steht Modernas weiterentwickeltes Vakzin mNEXSPIKE. BioNTech argumentiert in der beim Bundesgericht in Delaware eingereichten Klage, dass dieser Impfstoff Technologien nutzt, die ursprünglich in Mainz entwickelt wurden. Konkret geht es um ein Verfahren, das geringere Dosierungen bei hoher Wirksamkeit und besserer Lagerstabilität ermöglicht.
Der Schritt ist brisant, da mNEXSPIKE einen Großteil der Moderna-Umsätze in der laufenden Saison ausmachen soll. BioNTech fordert Schadensersatz und reagiert damit auch auf die rechtliche Offensive von Moderna, das bereits 2022 Klage gegen die Mainzer und ihren Partner Pfizer eingereicht hatte. Der Kampf um die Deutungshoheit und die Erträge der mRNA-Technologie geht damit in die nächste Runde.
Zahlen und Pipeline im Fokus
Neben dem Schlagabtausch im Gerichtssaal blicken Investoren auf den 10. März 2026. An diesem Datum wird BioNTech die detaillierten Ergebnisse für das Geschäftsjahr 2025 vorlegen. Die Umsatzprognose wurde zuletzt auf 2,6 bis 2,8 Milliarden Euro eingegrenzt.
Viel entscheidender für die langfristige Bewertung ist jedoch der Fortschritt in der Onkologie. Das Unternehmen treibt den Wandel vom Impfstoffhersteller zum breiten Krebsmedikamenten-Entwickler voran. Bis Ende 2026 sollen 15 klinische Studien der wichtigen Phase 3 laufen. Jüngste Daten zum Lungenkrebs-Kandidaten Gotistobart zeigten laut Unternehmensangaben Vorteile gegenüber der Standardchemotherapie. Analysten bewerten die Lage unterschiedlich: Während Goldman Sachs die Exekution der Strategie lobt, mahnte das Analysehaus Leerink zuletzt zur Vorsicht und sieht das Aufwärtspotenzial nach der jüngsten Erholung als begrenzt an.
Die aktuelle Marktlage
An der Börse spiegelt sich die Übergangsphase des Unternehmens wider. Zwar liegt die Aktie auf Zwölf-Monats-Sicht rund 10 Prozent im Minus, konnte seit Jahresbeginn jedoch wieder um gut 13 Prozent zulegen. Mit einem aktuellen Kurs von 93,30 Euro notiert das Papier über dem 50-Tage-Durchschnitt, hat aber zum 52-Wochen-Hoch bei knapp 109 Euro noch Boden gutzumachen.
Der 10. März wird zeigen, wie effizient BioNTech sein massives Kapitalpolster von 17,2 Milliarden Euro in marktreife Produkte umwandeln kann. Mit der Klage gegen Moderna signalisiert das Management zudem die Bereitschaft, seine technologische Basis aggressiv zu verteidigen. Für den weiteren Kursverlauf sind nun konkrete klinische Daten aus der späten Studienphase notwendig, um die Bewertung nachhaltig von den sinkenden Covid-Umsätzen abzukoppeln.
BioNTech-Aktie: Kaufen oder verkaufen?! Neue BioNTech-Analyse vom 28. Februar liefert die Antwort:
Die neusten BioNTech-Zahlen sprechen eine klare Sprache: Dringender Handlungsbedarf für BioNTech-Aktionäre. Lohnt sich ein Einstieg oder sollten Sie lieber verkaufen? In der aktuellen Gratis-Analyse vom 28. Februar erfahren Sie was jetzt zu tun ist.
BioNTech: Kaufen oder verkaufen? Hier weiterlesen...










